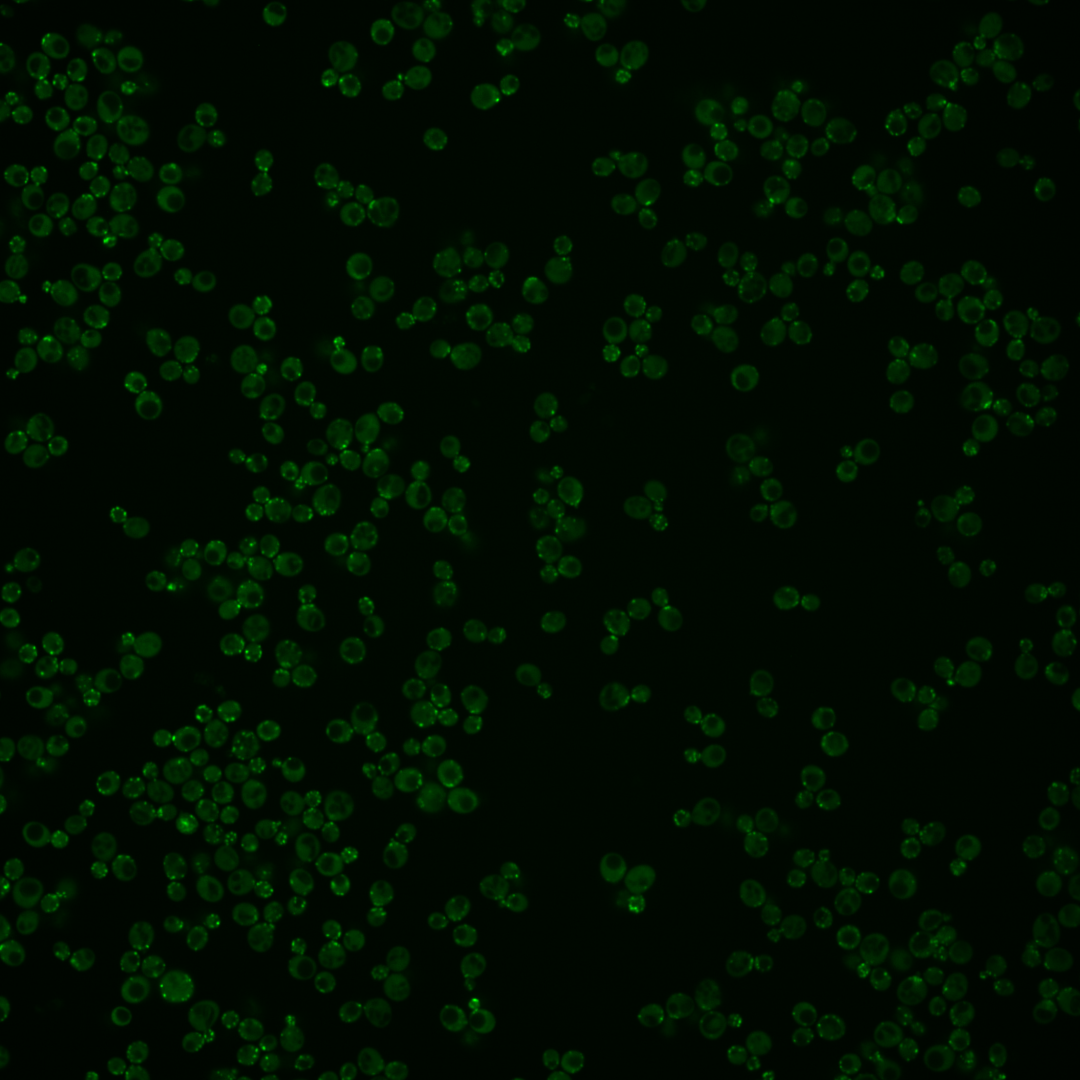
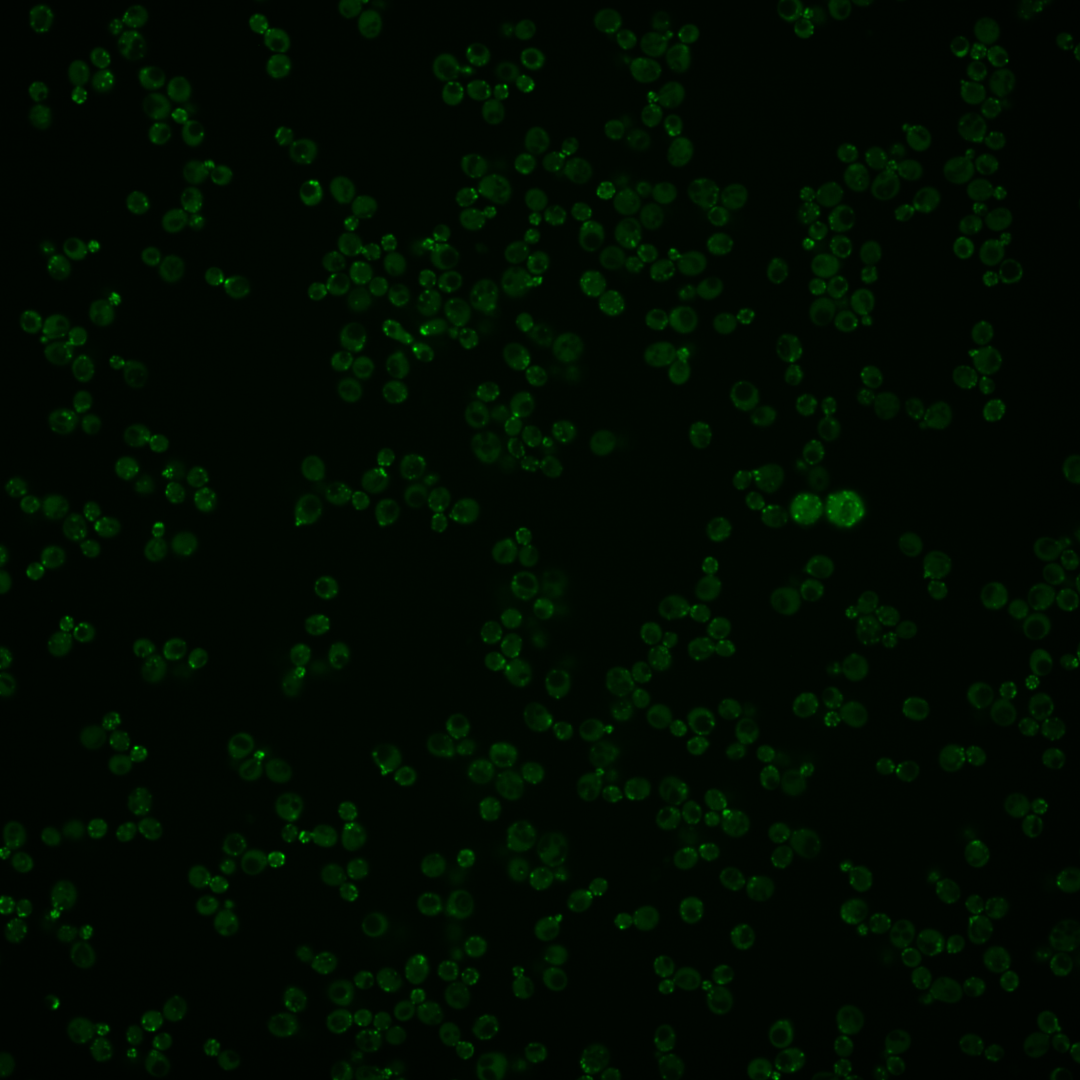
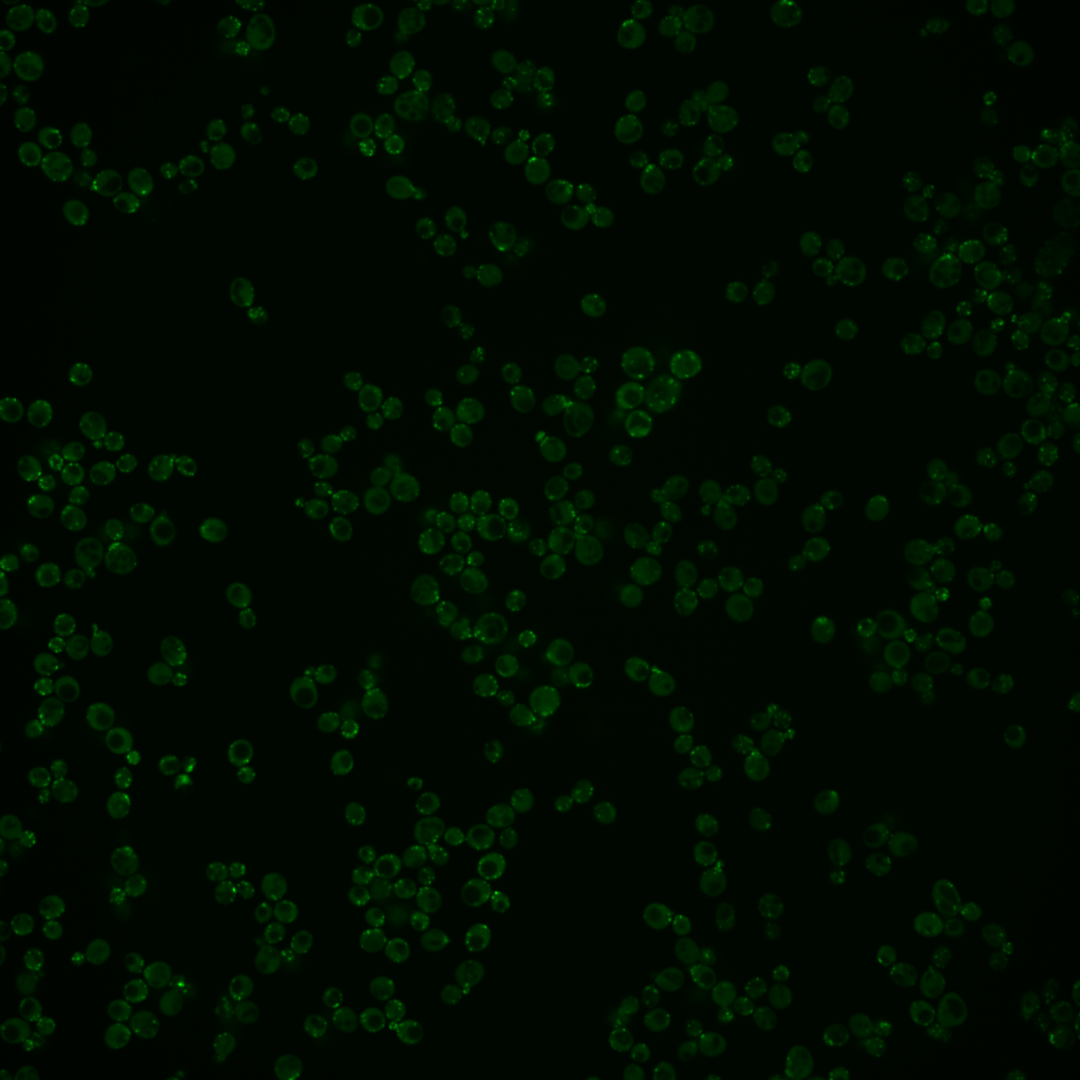
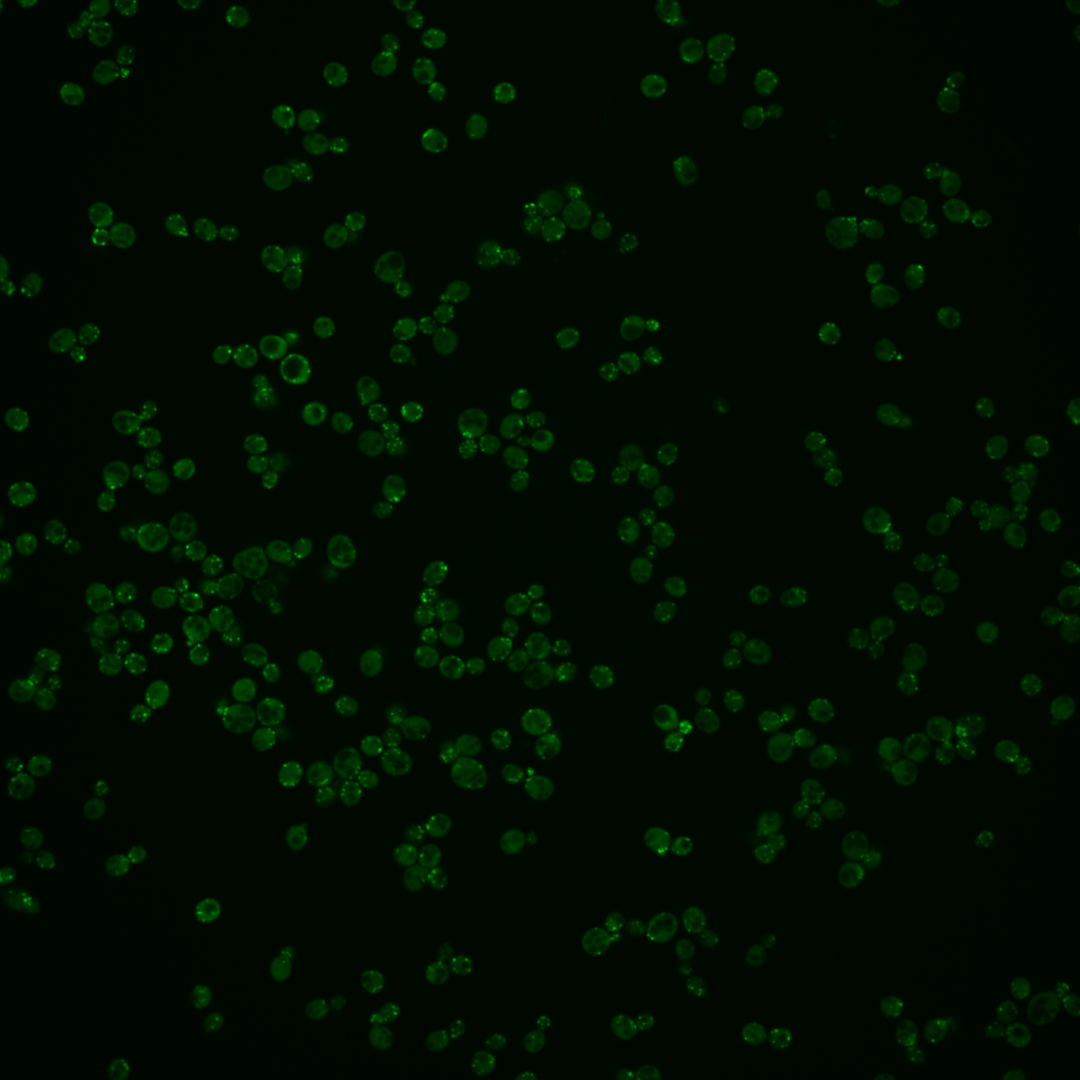
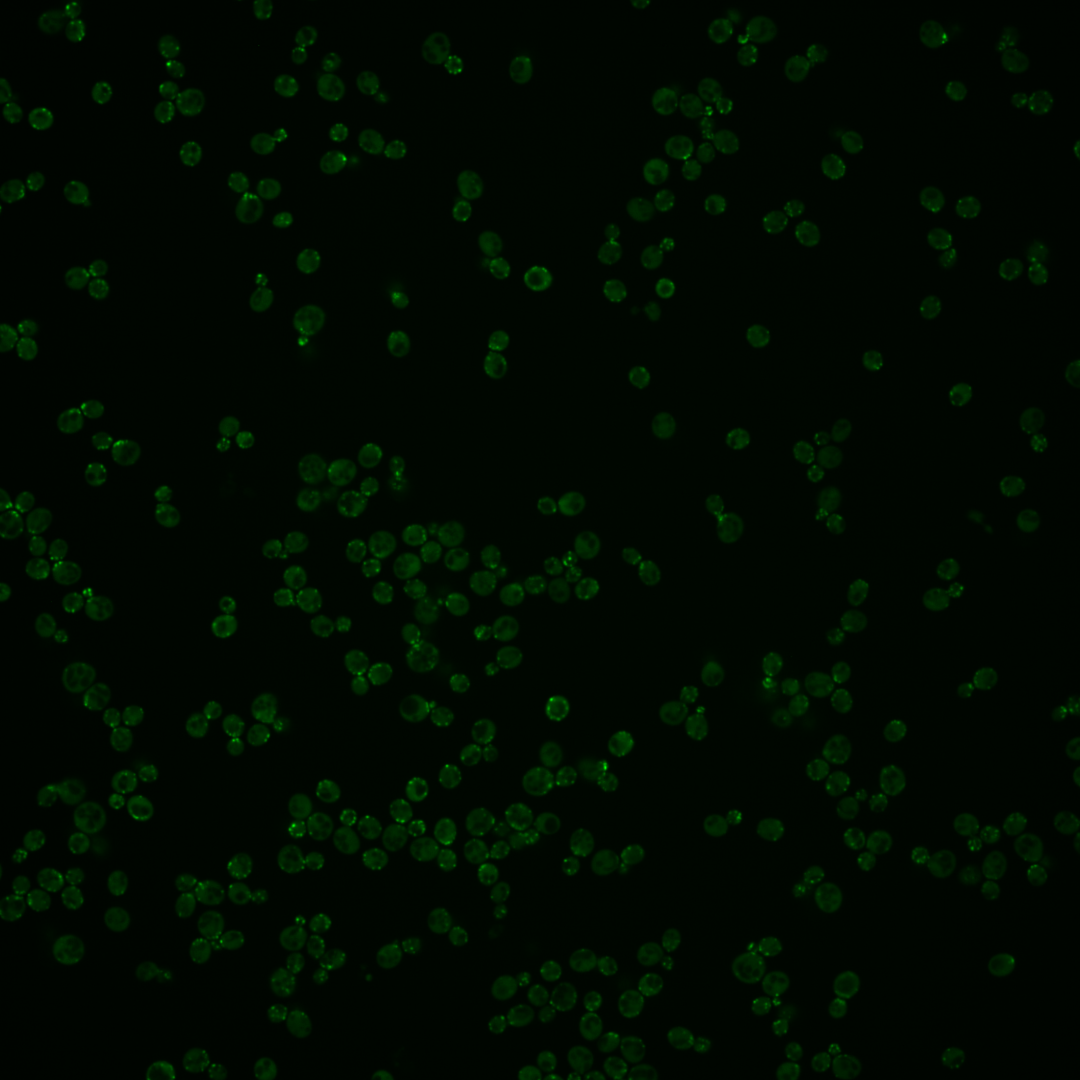

| Standard name | |
|---|---|
| Human Ortholog | |
| Description | Actin cortical patch component; interacts with the actin depolymerizing factor cofilin; inhibits elongation of aged ADP-actin filaments decorated with cofilin to maintain a high level of assembly-competent actin species; required to restrict cofilin localization to cortical patches; putative regulator of cytokinesis; contains WD repeats; protein increases in abundance and relocalizes from cytoplasm to plasma membrane upon DNA replication stress |
Micrographs




















































































Sub-cellular Localization
Yeast GFP Assignment
Protein Abundance
Localization Change
External localization resources
| ensLOC | DeepLoc | |||||||||||||||||||||||
|---|---|---|---|---|---|---|---|---|---|---|---|---|---|---|---|---|---|---|---|---|---|---|---|---|
| Localization | WT1 | WT2 | WT3 | RAP60 | RAP140 | RAP220 | RAP300 | RAP380 | RAP460 | RAP540 | RAP620 | RAP700 | HU80 | HU120 | HU160 | rpd3Δ_1 | rpd3Δ_2 | rpd3Δ_3 | WT1 | WT2 | WT3 | AF100 | AF140 | AF180 |
| Cortical Patches | 263 | 159 | 113 | 118 | 86 | 122 | 121 | 146 | 96 | 122 | 109 | 104 | 6 | 8 | 9 | 73 | 60 | 69 | 361 | 270 | 125 | 18 | 39 | 50 |
| Bud | 62 | 37 | 20 | 25 | 24 | 31 | 24 | 38 | 26 | 26 | 26 | 21 | 1 | 1 | 2 | 19 | 20 | 15 | 31 | 35 | 12 | 2 | 4 | 2 |
| Bud Neck | 0 | 0 | 0 | 0 | 0 | 0 | 0 | 0 | 0 | 0 | 0 | 0 | 0 | 0 | 0 | 0 | 0 | 0 | 4 | 1 | 1 | 0 | 0 | 0 |
| Bud Site | 0 | 3 | 0 | 0 | 0 | 1 | 0 | 0 | 0 | 1 | 1 | 1 | 0 | 0 | 0 | 0 | 0 | 0 | – | – | – | – | – | – |
| Cell Periphery | 11 | 19 | 6 | 9 | 5 | 7 | 1 | 10 | 4 | 7 | 9 | 7 | 1 | 2 | 0 | 6 | 5 | 5 | 0 | 0 | 0 | 0 | 0 | 0 |
| Cytoplasm | 92 | 69 | 29 | 14 | 18 | 22 | 21 | 32 | 12 | 15 | 9 | 14 | 4 | 8 | 7 | 29 | 25 | 41 | 21 | 12 | 6 | 0 | 1 | 1 |
| Endoplasmic Reticulum | 58 | 69 | 21 | 33 | 29 | 31 | 42 | 50 | 21 | 32 | 33 | 24 | 0 | 1 | 1 | 8 | 12 | 17 | 7 | 7 | 3 | 0 | 0 | 1 |
| Endosome | 12 | 0 | 4 | 1 | 1 | 3 | 0 | 2 | 1 | 4 | 1 | 5 | 1 | 0 | 0 | 0 | 1 | 1 | 40 | 38 | 23 | 3 | 2 | 7 |
| Golgi | 205 | 176 | 126 | 134 | 149 | 170 | 196 | 304 | 165 | 220 | 154 | 167 | 13 | 9 | 19 | 199 | 211 | 200 | 79 | 61 | 46 | 9 | 25 | 28 |
| Mitochondria | 26 | 6 | 1 | 8 | 2 | 25 | 28 | 20 | 49 | 48 | 116 | 54 | 1 | 0 | 2 | 26 | 19 | 8 | 5 | 3 | 2 | 2 | 1 | 0 |
| Nucleus | 0 | 0 | 1 | 1 | 1 | 0 | 2 | 1 | 0 | 1 | 0 | 1 | 1 | 0 | 0 | 0 | 0 | 0 | 0 | 0 | 0 | 0 | 0 | 0 |
| Nuclear Periphery | 0 | 0 | 0 | 0 | 1 | 0 | 1 | 0 | 0 | 2 | 0 | 1 | 0 | 0 | 0 | 0 | 0 | 0 | 2 | 1 | 0 | 0 | 0 | 0 |
| Nucleolus | 8 | 5 | 2 | 2 | 1 | 6 | 7 | 20 | 8 | 12 | 7 | 16 | 0 | 0 | 0 | 7 | 3 | 4 | 0 | 0 | 0 | 0 | 0 | 0 |
| Peroxisomes | 3 | 0 | 0 | 3 | 0 | 1 | 3 | 0 | 0 | 0 | 0 | 1 | 0 | 0 | 0 | 0 | 0 | 0 | 6 | 5 | 4 | 0 | 3 | 3 |
| SpindlePole | 2 | 0 | 0 | 2 | 0 | 1 | 1 | 5 | 3 | 1 | 0 | 0 | 0 | 0 | 0 | 8 | 3 | 2 | 5 | 6 | 2 | 0 | 0 | 0 |
| Vac/Vac Membrane | 9 | 11 | 12 | 4 | 5 | 7 | 3 | 24 | 6 | 11 | 4 | 14 | 0 | 1 | 0 | 15 | 15 | 10 | 2 | 7 | 2 | 1 | 0 | 0 |
| Unique Cell Count | 476 | 368 | 210 | 196 | 204 | 263 | 286 | 458 | 243 | 301 | 248 | 259 | 21 | 22 | 28 | 260 | 263 | 270 | 571 | 455 | 236 | 41 | 81 | 100 |
| Labelled Cell Count | 751 | 554 | 335 | 354 | 322 | 427 | 450 | 652 | 391 | 502 | 469 | 430 | 28 | 30 | 40 | 390 | 374 | 372 | 571 | 455 | 236 | 41 | 81 | 100 |
Yeast GFP Assignment
Protein Abundance
| Screen | WT1 | WT2 | WT3 | RAP60 | RAP140 | RAP220 | RAP300 | RAP380 | RAP460 | RAP540 | RAP620 | RAP700 | HU80 | HU120 | HU160 | rpd3Δ_1 | rpd3Δ_2 | rpd3Δ_3 | AF100 | AF140 | AF180 |
|---|---|---|---|---|---|---|---|---|---|---|---|---|---|---|---|---|---|---|---|---|---|
| Mean Cell GFP Intensity (1e-4) | 18.2 | 26.2 | 20.1 | 18.7 | 22.1 | 22.6 | 21.6 | 22.3 | 20.5 | 21.7 | 20.7 | 21.9 | 30.0 | 25.5 | 25.4 | 39.2 | 42.0 | 38.4 | – | 27.4 | 26.9 |
| Std Deviation (1e-4) | 4.5 | 6.3 | 4.6 | 4.0 | 5.4 | 5.9 | 5.4 | 5.6 | 5.8 | 6.7 | 6.1 | 6.8 | 10.8 | 9.3 | 8.3 | 13.9 | 14.2 | 13.1 | – | 8.8 | 12.9 |
| Intensity Change (Log2) | – | – | – | -0.1 | 0.14 | 0.17 | 0.1 | 0.15 | 0.03 | 0.11 | 0.04 | 0.12 | 0.58 | 0.34 | 0.34 | 0.96 | 1.06 | 0.93 | – | 0.45 | 0.42 |
Localization Change
| Localization | RAP60 | RAP140 | RAP220 | RAP300 | RAP380 | RAP460 | RAP540 | RAP620 | RAP700 | HU80 | HU120 | HU160 | rpd3Δ_1 | rpd3Δ_2 | rpd3Δ_3 |
|---|---|---|---|---|---|---|---|---|---|---|---|---|---|---|---|
| Cortical Patches | 1.3 | -2.4 | -1.6 | -2.5 | -5.4 | -3.0 | -3.0 | -2.1 | -2.9 | -2.2 | -1.6 | -2.2 | -5.7 | -7.0 | -6.3 |
| Bud | 1.0 | 0.7 | 0.8 | -0.4 | -0.5 | 0.4 | -0.3 | 0.3 | -0.5 | 0 | 0 | 0 | -0.9 | -0.7 | -1.7 |
| Bud Neck | 0 | 0 | 0 | 0 | 0 | 0 | 0 | 0 | 0 | 0 | 0 | 0 | 0 | 0 | 0 |
| Bud Site | 0 | 0 | 0 | 0 | 0 | 0 | 0 | 0 | 0 | 0 | 0 | 0 | 0 | 0 | 0 |
| Cell Periphery | 0.9 | -0.3 | -0.1 | 0 | -0.5 | 0 | -0.4 | 0.5 | -0.1 | 0 | 0 | 0 | -0.4 | 0 | 0 |
| Cytoplasm | -2.2 | -1.6 | -1.9 | -2.4 | -2.8 | -3.3 | -3.5 | -3.9 | -3.1 | 0 | 0 | 0 | -0.9 | -1.5 | 0.4 |
| Endoplasmic Reticulum | 2.0 | 1.3 | 0.6 | 1.5 | 0.4 | -0.5 | 0.2 | 1.1 | -0.3 | 0 | 0 | 0 | -3.1 | -2.3 | -1.5 |
| Endosome | 0 | 0 | 0 | 0 | 0 | 0 | 0 | 0 | 0 | 0 | 0 | 0 | 0 | 0 | 0 |
| Golgi | 1.8 | 2.8 | 1.0 | 2.0 | 1.6 | 1.7 | 3.1 | 0.5 | 1.0 | 0.2 | -1.7 | 0.8 | 3.9 | 4.8 | 3.3 |
| Mitochondria | 0 | 0 | 4.3 | 4.4 | 2.7 | 6.7 | 5.8 | 11.3 | 6.8 | 0 | 0 | 0 | 4.4 | 3.6 | 0 |
| Nucleus | 0 | 0 | 0 | 0 | 0 | 0 | 0 | 0 | 0 | 0 | 0 | 0 | 0 | 0 | 0 |
| Nuclear Periphery | 0 | 0 | 0 | 0 | 0 | 0 | 0 | 0 | 0 | 0 | 0 | 0 | 0 | 0 | 0 |
| Nucleolus | 0 | 0 | 0 | 0 | 2.3 | 0 | 2.1 | 0 | 2.9 | 0 | 0 | 0 | 0 | 0 | 0 |
| Peroxisomes | 0 | 0 | 0 | 0 | 0 | 0 | 0 | 0 | 0 | 0 | 0 | 0 | 0 | 0 | 0 |
| SpindlePole | 0 | 0 | 0 | 0 | 0 | 0 | 0 | 0 | 0 | 0 | 0 | 0 | 0 | 0 | 0 |
| Vacuole | -1.9 | -1.7 | -1.7 | -3.0 | -0.3 | -1.8 | -1.1 | -2.4 | -0.1 | 0 | 0 | 0 | 0 | 0 | -1.0 |
External localization resources
Images






























Protein Concentration and Protein Localization Data
| R1 | R2 | R3 | ||||||||||||||||
|---|---|---|---|---|---|---|---|---|---|---|---|---|---|---|---|---|---|---|
| G1 Pre-START | G1 Post-START | S/G2 | Metaphase | Anaphase | Telophase | G1 Pre-START | G1 Post-START | S/G2 | Metaphase | Anaphase | Telophase | G1 Pre-START | G1 Post-START | S/G2 | Metaphase | Anaphase | Telophase | |
| Concentration | 15.4491 | 15.3667 | 16.1763 | 14.531 | 13.8738 | 15.0051 | 24.6628 | 20.8958 | 23.5461 | 22.862 | 22.5148 | 21.4372 | 20.6307 | 18.2925 | 18.1602 | 16.8367 | 18.6626 | 19.1425 |
| Actin | 0.6109 | 0.6079 | 0.8188 | 0.8083 | 0.7589 | 0.6826 | 0.6047 | 0.6121 | 0.7864 | 0.6931 | 0.6631 | 0.6048 | 0.7046 | 0.6649 | 0.8783 | 0.7914 | 0.8391 | 0.7315 |
| Bud | 0.0021 | 0.0074 | 0.0225 | 0.0169 | 0.0038 | 0.0019 | 0.002 | 0.004 | 0.0098 | 0.0108 | 0.0039 | 0.0007 | 0.0027 | 0.0064 | 0.0245 | 0.0248 | 0.0155 | 0.0009 |
| Bud Neck | 0.0021 | 0.0016 | 0.0015 | 0.0021 | 0.001 | 0.0038 | 0.0011 | 0.0014 | 0.0008 | 0.0009 | 0.0013 | 0.0031 | 0.0012 | 0.0036 | 0.0007 | 0.0041 | 0.0012 | 0.0068 |
| Bud Periphery | 0.0018 | 0.0058 | 0.0143 | 0.0091 | 0.0024 | 0.0019 | 0.0019 | 0.0021 | 0.0104 | 0.0271 | 0.0031 | 0.0006 | 0.002 | 0.0027 | 0.0227 | 0.0298 | 0.0218 | 0.0007 |
| Bud Site | 0.0043 | 0.0285 | 0.0161 | 0.0053 | 0.0015 | 0.0013 | 0.0033 | 0.0352 | 0.0115 | 0.0016 | 0.0022 | 0.0006 | 0.0054 | 0.0379 | 0.0082 | 0.004 | 0.0024 | 0.0006 |
| Cell Periphery | 0.0002 | 0.0004 | 0.0003 | 0.0009 | 0.0001 | 0.0002 | 0.0008 | 0.0004 | 0.0004 | 0.0003 | 0.0002 | 0.0002 | 0.0002 | 0.0004 | 0.0003 | 0.0004 | 0.0005 | 0.0002 |
| Cytoplasm | 0.0077 | 0.0727 | 0.0194 | 0.0547 | 0.0088 | 0.0068 | 0.0148 | 0.0376 | 0.0174 | 0.1384 | 0.0187 | 0.0059 | 0.0087 | 0.07 | 0.0026 | 0.0549 | 0.0328 | 0.0043 |
| Cytoplasmic Foci | 0.0438 | 0.0777 | 0.025 | 0.0206 | 0.021 | 0.0274 | 0.0321 | 0.0551 | 0.0251 | 0.0083 | 0.0275 | 0.0239 | 0.028 | 0.0655 | 0.0091 | 0.0128 | 0.0085 | 0.0262 |
| Eisosomes | 0.0004 | 0.0001 | 0.0002 | 0.0001 | 0.0002 | 0.0003 | 0.0005 | 0.0003 | 0.0002 | 0.0002 | 0.0003 | 0.0005 | 0.0015 | 0.0002 | 0.0002 | 0.0001 | 0.0017 | 0.0008 |
| Endoplasmic Reticulum | 0.0029 | 0.0011 | 0.0007 | 0.0004 | 0.0004 | 0.0008 | 0.001 | 0.001 | 0.0017 | 0.0014 | 0.0022 | 0.001 | 0.0005 | 0.0004 | 0.0001 | 0.0019 | 0.0011 | 0.0004 |
| Endosome | 0.047 | 0.0402 | 0.0162 | 0.0114 | 0.0227 | 0.0304 | 0.0258 | 0.0208 | 0.0122 | 0.0043 | 0.022 | 0.0217 | 0.0203 | 0.0171 | 0.0029 | 0.0085 | 0.0125 | 0.0181 |
| Golgi | 0.2271 | 0.1224 | 0.0515 | 0.0605 | 0.096 | 0.2282 | 0.2969 | 0.2065 | 0.1098 | 0.1095 | 0.2429 | 0.3267 | 0.2033 | 0.1027 | 0.043 | 0.0609 | 0.0542 | 0.2007 |
| Lipid Particles | 0.0099 | 0.0043 | 0.0011 | 0.0006 | 0.0288 | 0.0042 | 0.0054 | 0.0031 | 0.0028 | 0.0007 | 0.001 | 0.0009 | 0.0066 | 0.0013 | 0.0012 | 0.002 | 0.004 | 0.0015 |
| Mitochondria | 0.0124 | 0.0021 | 0.0024 | 0.0016 | 0.0048 | 0.0047 | 0.0046 | 0.0037 | 0.0018 | 0.0008 | 0.0027 | 0.0042 | 0.0042 | 0.0026 | 0.0008 | 0.0009 | 0.0016 | 0.0025 |
| None | 0.0026 | 0.0004 | 0.0008 | 0.0002 | 0.0014 | 0.0001 | 0.0001 | 0.0002 | 0.0002 | 0.0002 | 0.0001 | 0.0001 | 0.0001 | 0.0003 | 0 | 0.0002 | 0.0001 | 0.0001 |
| Nuclear Periphery | 0.0074 | 0.0006 | 0.0007 | 0.0003 | 0.0056 | 0.0006 | 0.0002 | 0.0002 | 0.0002 | 0.0002 | 0.0006 | 0.0001 | 0.0001 | 0.0002 | 0.0001 | 0.0002 | 0.0004 | 0.0001 |
| Nucleolus | 0.0004 | 0.0001 | 0.0001 | 0.0001 | 0.0015 | 0 | 0.0001 | 0 | 0.0001 | 0 | 0 | 0 | 0 | 0.0001 | 0 | 0 | 0 | 0 |
| Nucleus | 0.0015 | 0.0004 | 0.0007 | 0.0008 | 0.0015 | 0.0001 | 0.0001 | 0.0002 | 0.0003 | 0.0001 | 0.0002 | 0.0001 | 0.0001 | 0.0005 | 0.0001 | 0.0001 | 0.0001 | 0 |
| Peroxisomes | 0.0095 | 0.0232 | 0.0053 | 0.0031 | 0.006 | 0.0034 | 0.0033 | 0.0152 | 0.0079 | 0.0015 | 0.007 | 0.0044 | 0.0096 | 0.0219 | 0.0044 | 0.002 | 0.0014 | 0.0038 |
| Punctate Nuclear | 0.0027 | 0.001 | 0.001 | 0.0003 | 0.0319 | 0.0003 | 0.0001 | 0.0002 | 0.0002 | 0.0001 | 0.0003 | 0.0001 | 0.0001 | 0.0006 | 0.0001 | 0.0002 | 0.0002 | 0.0001 |
| Vacuole | 0.0017 | 0.0013 | 0.0009 | 0.0023 | 0.0006 | 0.0005 | 0.0005 | 0.0004 | 0.0007 | 0.0001 | 0.0004 | 0.0002 | 0.0002 | 0.0004 | 0.0004 | 0.0005 | 0.0003 | 0.0004 |
| Vacuole Periphery | 0.0017 | 0.0005 | 0.0004 | 0.0004 | 0.0009 | 0.0004 | 0.0005 | 0.0003 | 0.0002 | 0.0001 | 0.0003 | 0.0003 | 0.0003 | 0.0002 | 0.0001 | 0.0001 | 0.0003 | 0.0003 |
Sequencing Data
| R1 | R2 | |||||||||
|---|---|---|---|---|---|---|---|---|---|---|
| G1 Post-START | S/G2 | Metaphase | Anaphase | Telophase | G1 Post-START | S/G2 | Metaphase | Anaphase | Telophase | |
| Gene Expression | 72.2467 | 54.9766 | 60.9945 | 81.4023 | 61.5442 | 73.4002 | 62.1978 | 73.7598 | 86.3206 | 83.3591 |
| Translational Efficiency | 1.2573 | 1.2255 | 1.1263 | 1.2764 | 1.4092 | 1.2828 | 1.244 | 1.0784 | 1.2141 | 1.1624 |
Hit Data
| Dataset | Hit |
|---|---|
| Protein Concentration | ✘ |
| Protein Localization | ✔ |
| Gene Expression | ✘ |
| Translational Efficiency | ✘ |
Endocytosis
| Temp | Actin Patch (Sac6-tdTomato) | Cortical Patch (Sla1-GFP) | Late Endosome (Snf7-GFP) | Vacuole (Vph1-GFP) |
|---|---|---|---|---|
| 37℃ | ||||
| RT |
Cell Cycle Omics
CYCLoPs (Aip1-GFP)
| Gene / Allele | Actin Patch (Sac6-tdTomato) | Cortical Patch (Sla1-GFP) | Late Endosome (Snf7-GFP) | Vacuole (Sac6-tdTomato) |
|---|
| Gene | Images |
|---|
| Gene | Images |
|---|
Images are not yet available
Images are not yet available